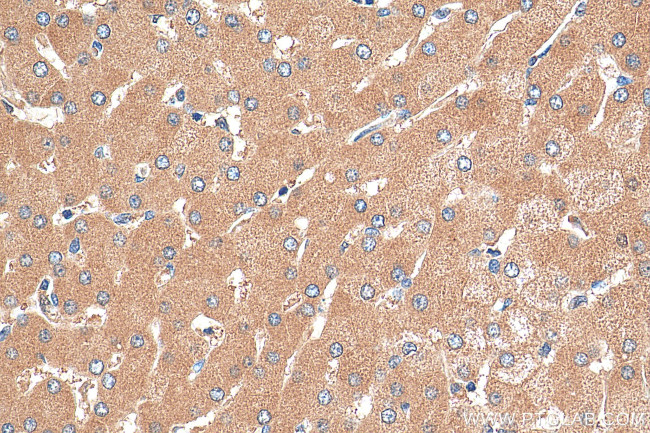
PTPRD Antibody in Immunohistochemistry (Paraffin) (IHC (P))

Search
Proteintech
PTPRD Polyclonal Antibody
{{$productOrderCtrl.translations['antibody.pdp.commerceCard.promotion.promotions']}}
{{$productOrderCtrl.translations['antibody.pdp.commerceCard.promotion.viewpromo']}}
{{$productOrderCtrl.translations['antibody.pdp.commerceCard.promotion.promocode']}}: {{promo.promoCode}} {{promo.promoTitle}} {{promo.promoDescription}}. {{$productOrderCtrl.translations['antibody.pdp.commerceCard.promotion.learnmore']}}
产品信息
27941-1-AP
种属反应
宿主/亚型
分类
类型
抗原
偶联物
形式
浓度
纯化类型
保存液
内含物
保存条件
运输条件
产品详细信息
Immunogen sequence: GNSAGGLQHR VTAKTAPDVL RTKPAFIGKT NLDGMITVQL PEVPANENIK GYYIIIVPLK KSRGKFIKPW ESPDEMELDE LLKEISRKRR SIRYGREVEL KPYIAAHFDV LPTEFTLGDD KHYGGFTNKQ LQSGQEY
靶标信息
PTPRD is a member of the protein tyrosine phosphatase (PTP) family. PTPs are known to be signaling molecules that regulate a variety of cellular processes including cell growth, differentiation, mitotic cycle, and oncogenic transformation. This PTP contains an extracellular region, a single transmembrane segment and two tandem intracytoplasmic catalytic domains, and thus represents a receptor-type PTP. The extracellular region of this protein is composed of three Ig-like and eight fibronectin type III-like domains. Studies of the similar genes in chicken and fly suggest the role of this PTP is in promoting neurite growth, and regulating neurons axon guidance.
仅用于科研。不用于诊断过程。未经明确授权不得转售。
篇参考文献 (0)
生物信息学
蛋白别名: protein tyrosine phosphatase, receptor type, D; protein tyrosine phosphatase, receptor type, delta polypeptide; Protein-tyrosine phosphatase delta; rceptor-type tyrosine-protein phosphatase delta; Receptor-type tyrosine-protein phosphatase delta; unnamed protein product
基因别名: 1110002J03Rik; 3000002J10Rik; B230219D21Rik; HPTP; HPTPD; HPTPDELTA; PTPD; PTPRD; R-PTP-delta; RPTPDELTA
UniProt ID: (Human) P23468, (Mouse) Q64487
Entrez Gene ID: (Human) 5789, (Mouse) 19266, (Rat) 313278